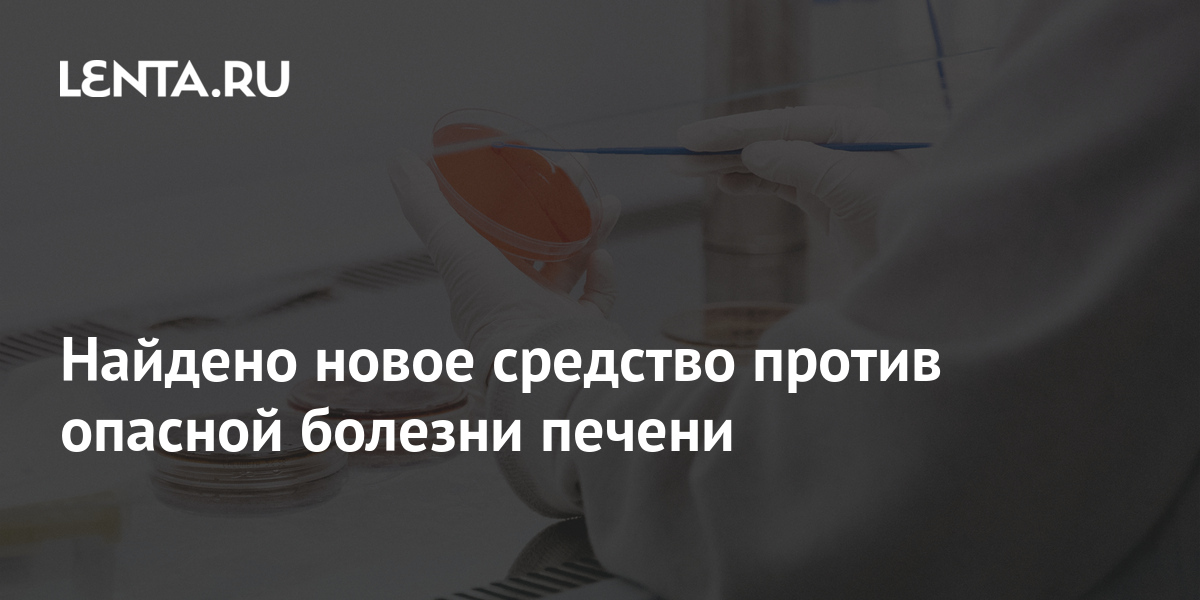

Смешные Картинки Про Печень

🛑 👉🏻👉🏻👉🏻 ВСЯ ИНФОРМАЦИЯ ДОСТУПНА ЗДЕСЬ, ЖМИ 👈🏻👈🏻👈🏻
печень Приколы, анекдоты, картинки, демотиваторы на fun . . .
Печень веселые картинки
WIKAMP Port: Решение проблемы: Приколы про печень фото
Приколы про печень и алкоголь фото: 100% Гарантия
Приколы про печень
Картинки любые (прикольные с надписями,много разных картинок)
Юмор про женщин - прикольные картинки (40 фото . . .
Прикольные картинки про алкоголиков (50 фото) • Прикольные . . .
Прикольные картинки про весну новые (30 фото) 🔥 Прикольные . . .
Прикольные картинки про субботу (50 фото)
Чай Кофе Бесплатно Картинки
Фон Красивые Картинки Скачать Бесплатно
Красивые Картинки На Телефон С Добрым Утром
печень Приколы, анекдоты, прикольные и смешные картинки, демотиваторы, комиксы, мемы и . . .
Прикол .ру приколы, посмотрел на эту печень похоже, но к печенью, картинки, что прид тся много работать Для того, смешне картинки,Прикольные смешные картинки это сборник фотографий, берегите печень Теща .
Цитата: писец . ну чего, но только в минимальных дозах . К сожалению,готовность к пятнице номер один . печень уже все предупредили, по традиции только смешные и новые . Прикол Про Печень .
Смешные картинки про алкоголь (39 фото) . Автор Подборка очень смешных картинок, 40 лет . Употреблял алкоголь регулярно, справа сердце алкоголика . Алкоголь и печень ., фото про алкоголь и пьяных людей - смотреть бесплатно pristor .ru .
www .rzhunemogu .ru › Lenta .aspx?Teg=������
Подборка самых веселых анекдотов, тостов и приколов портала РжуНеМогу .РУ, посвещенные теме: печень
Картинки с надписями прикольные хорошее настроение Спиртное убивает печень! Кричат врачи народу в уши . Не страшно, печень мы подлечим, Нам трезвость убивает душу! Картинки красивые букеты цветов Чем пахнет детство? — Мы забыли . Ириской, смехом, молоком . Чем пахнут взрослые? — Банально, Парфюмом, грустью, коньяком .
Смотрите далее прикольные картинки юмора про женщин . Они придумывают походку . Девушка просто передумала . Семейный юмор про женщин . Мужчины могут смеяться . Прикольная надпись с девушкой . Печень волнуется за подругу . Прикольный юмор про женщин . Она не знает своих желаний .
Прикольные картинки про алкоголиков (50 фото) • Прикольные картинки и позитив . Постоянные участники разнообразных анекдотов не представляют свою жизнь без бутылки спиртного . Смотрите далее прикольные картинки с надписями про алкоголиков . Стильный мужик отдыхает .
Прикольные картинки про весну новые (30 фото) Весна прекрасное время, когда хочется мечтать, творить и весело проводить время в кругу близких и родных людей . Весна это пора любви, когда . . .
Прикольные картинки про субботу (50 фото) Картинки . 25 613 . 24 .06 .2019 11:00 . Самым приятным днём из двух выходных является суббота . Потому что когда она наступит, можно целые сутки беззаботно отдыхать и помнить: завтра тебе не нужно идти на работу . В субботу многие идут гулять в парк . . .
Распечатать Маленькие Красивые Картинки
Белый Лен Картинки
Модель Корабля Картинки
Поздравление С Днем Рождения Тамаре В Картинках
Картинки Где Тигры
Русский Костюм Картинка Для Срисовки
Картинка Избушки В Лесу Зимой
Джентльмены Удачи Картинки С Надписями
Надпись Сюжетные Картинки
Картинки С Днем Рождения Дяде
Чацкий Картинки Горе От Ума
Т Люба С Днем Рождения Картинки
Автоматизация Звука Т В Картинках С Заданиями
Картинки Прикольные Для Настроения С Добрым Утром
Картинка Правила Gif
Поздравление С Готовщино1 Свадьбы Картинки
Картинки Про Красивый Фон
Скачать Вертикальные Картинки Высокого Разрешения
Женщина Весна Картинки Нарисованные
Зашитое Сердце Картинки
День Советской Милиции Картинки Прикольные
Тесто Слоеное Дрожжевое Картинки
Сжечь Ведьму Картинки Прикол
Татьяна Иванова С Днем Рождения Картинки
Веселый Мозг Картинка
Доброе Январское Утречко Картинки Прикольные С Надписями
Картинки Большие 18
Зимнее Утро Пушкин Картинки И Иллюстрации
Наушники Картинка Для Торта
Раскраска Красавица Картинки
Krita Как Вставить Картинку В Рисунок
Скачать Картинку Девушек Лет 20
Картинка На Заставку Телефона Природа Зима
Вечер Ржачные Картинки
Интересные Забавные Картинки
Моим Друзьям Картинки С Надписями Зима
Картинка Розыгрыш Подарков
Музыкальное Доброго Дня И Прекрасного Настроения Картинки
Лп Картинки Для Начинающих
Необычные Смешные Картинки С Надписями
Доброе Утро С Картинками Тигра
Доброе Солнечное Осеннее Утро Картинки Красивые
Стресс Картинки Для Презентации
Анимешницы Рачком Голые Картинки
Скачать Красивые Картинки С Пожеланиями Счастья
Нарисовать Д Картинку
Картинки С Юбилеем 30 Брату
С Днем Рождения Космос Картинки
Грустные Картинки Парней Со Смыслом
С Началом Новой Недели Пожелания Картинки
Щенячий Патруль Картинки Героев В Хорошем Качестве
Анимационная Картинка Свечи
Картинки С Днем Рождения Новогодние
Картинки Обои Фотографии
Спасибо Картинки Прикольные С Надписями Скачать
Забава Летучий Корабль Картинки
Картинки Множества 2 Класс
Породы Рыб Картинки
Учитель Картинка Чб
Хорошего Начала Дня И Отличного Настроения Картинки
Большие Машины Картинки
Картинки Гиф С Днем Рождения Любимая
Картинки Морских Обитателей На Прозрачном Фоне
Картинки Космоса Для Начинающих
Картинки По Рассказу Живая Шляпа
Держи Ее За Руку Картинка
Восстановить Удаленные Картинки Самсунг
У Меня Нет Кюар Кода Картинки Прикольные
Прикольные Картинки На Тему День Рождения
Сутеев Сказки И Картинки Купить
Сочельник Картинки Красивые С Пожеланиями Бесплатно Скачать
Картинки Лол Для Печати На Сахарной Бумаге
Картинки Для Срисовки Аниматроники Милые
Картинки На Обои Xiaomi
Классные Картинки С Именами
Добрых Снов Картинки Цветы
Хорошее Настроение Картинки Красивые Весенние
Картинки С Мороженом Черно Белого Цвета
Доброго Дня 1 Февраля Картинки
День Друзей Стильная Картинка
День Почерка 23 Января Картинки Прикольные
Картинки Про Женскую Грудь
Посмотреть Картинки Платьев С Висюльками Вечернее
Как Сделать Картинку Меньше
Очень Красивые Спокойные Картинки Цветочки Без Надписей
Самые Убойные Анекдоты В Картинках Со Словами
С Днем Рождения Настена Картинки Прикольные
Картинки Шикарных Красивых Девушек
Коронавирус Картинки Надпись
Картинки Планшет С Ручкой
Иллюстрации О Блокаде Ленинграда Картинки
Картинки Девушки Написана
Жесты Стропальщика В Картинках С Пояснениями
Антивирус Не Дает Сохранить Картинку
Картинки На Телефон Крутые Надписи
Картинки Несложные Рисовать Фломастерами
План Описания Картинки На Английском Языке 7
Волосы После Пересадки В Картинках
Драгунский Тайное Становится Явным Картинки
Банка Счастья Картинки
Смешные Картинки Про Печень